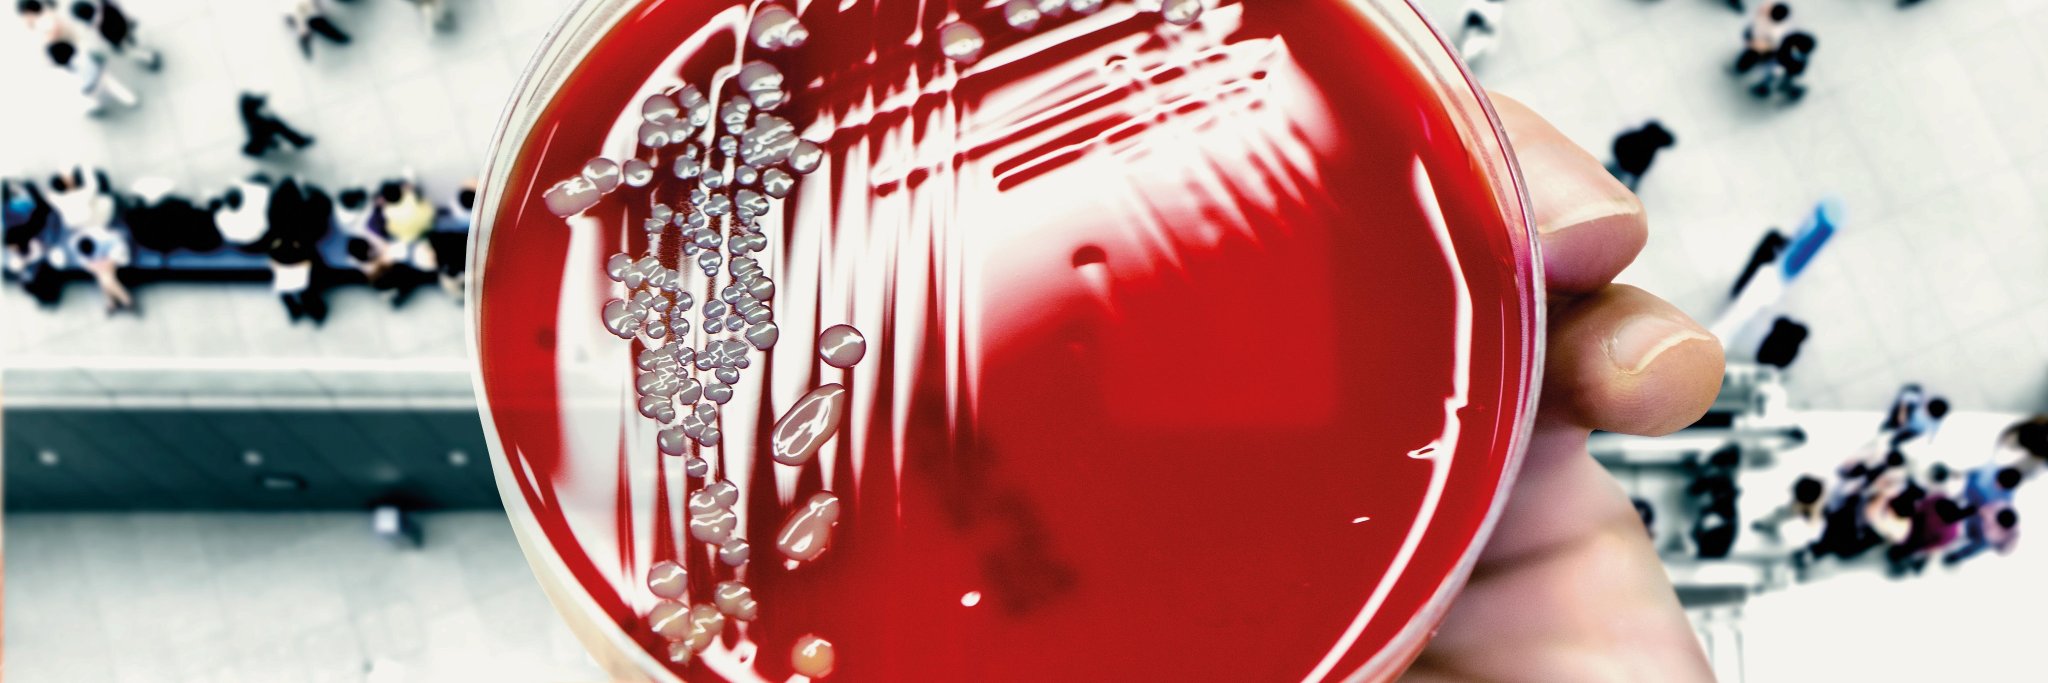
Utr. Life Sciences banner

Utr. Life Sciences
1.3K posts

Utr. Life Sciences
@UtrechtLS
Utrecht Life Sciences is an open innovation network of academia, government and biobusiness that drives innovations in human and veterinary health care.
Utrecht, Netherlands Katılım Mayıs 2011
236 Takip Edilen741 Takipçiler
Utr. Life Sciences retweetledi

Increasing the quality of the Dutch entrepreneurial ecosystem with more inclusion #stateofDutchTech #inclusion #entrepreneurialecosystems #winecon lnkd.in/eqwg2DyH
English

#S4L2022 , the Science for Life conference is off to a great start, over 400 life scientists in the audience, mostly young investigators (and >100 posters presented this afternoon!)
English

Check out this very exciting lineup from the fundamental life sciences! There are still spots available for the 2022 Science for Life conference on november 14. Will you join us? uu.nl/en/S4L2022
English

One week to go until the Science for Life conference 2021. Over 400 participants, an exciting international line-up of speakers, break-out and poster sessions. Free of charge and right on your doorstep! WIll you join us next monday?
uu.nl/en/S4L2021
English

Congratulations @josmalda with this fab award! It proves once more that @rmutrecht is a global key player in the field of #biofabrication
Intl Soc Biofab@ISBioFab
Congratulations to all the 2021 @ISBioFab award winners! Awards will be presented at the upcoming @biofab2021 conference. Come listen to the exciting developments of the biofabrication field! @josmalda @liliangouyang @esgisss @MakingSteph @MiguCastilho
English
Utr. Life Sciences retweetledi

So happy to share that I have joined the Biofabrication lab @UMCU_Intl @UtrechtUni as a PhD student with @MiguCastilho and @josmalda.
I am very grateful for the warm welcome amid these strange times! Let's help repair some hearts with #3Dprinting!🫀🦾 @brav3_eu


English
Utr. Life Sciences retweetledi

Op zoek naar een onderwerp voor je profielwerkstuk (4-6 VWO)?: wij geven 12 februari een online masterclass over 3D printen van levende weefsels. Meld je nu aan!
u-talent.nl/activiteit/3d-… @UMCUtrecht @RMUtrecht @UtrechtUni #profielwerkstuk @scholieren #PWS @Examenbundel
Nederlands
Utr. Life Sciences retweetledi

"Acquiring the mitochondria was neither prologue nor finale of the eukaryotic evolution, but rather an important plot twist in-between", says @JulianVosseberg. uu.nl/en/news/timeli… @UtrechtUni @UtrechtLS
English

There is little reason to believe that the coronavirus SARS-CoV-2 will go away any time soon, even when vaccines become available. Utrecht Prof. Hans Heesterbeek explains theconversation.com/covid-19-will-…
English
Utr. Life Sciences retweetledi

Hoe stimuleer je nieuwe vormen van landbouw, vergroot je tegelijkertijd bewustwording over gezonde voeding én geef je een impuls aan de ontwikkeling van nieuwe kennis? Met die vraag kunnen 6 promovendi bij de UU aan de slag. 🌱🍴🚜 @RegioFoodValley #Werk uu.nl/nieuws/zes-ond…
Nederlands
Utr. Life Sciences retweetledi

Utrecht Molecular Immunology Hub scientists and coronavirus experts - Bernd Jan Bosch and Raoul de Groot - aim to identify Ab's that can neutralize the novel coronavirus uu.nl/en/research/ut…

English
Utr. Life Sciences retweetledi

Zojuist inspirerend gesprek gehad met @bruno_bruins @MinVWS over de rol die Nederland internationaal kan pakken in de strijd tegen #AMR. @ncohnl

Nederlands
Utr. Life Sciences retweetledi

Met een elektronenmicroscoop kun je de állerkleinste details zien. Bijvoorbeeld hoe een virus een cel infecteert, of het effect van medicijnen binnen een cel. Omdat zo'n microscoop heel duur is, werken we samen binnen @ProjectNemi. Lees meer > umcutrecht.nl/nl/Nieuws/Elek…

Nederlands
Utr. Life Sciences retweetledi

Wordt ik vrolijk van. Zo vlak voor kerst strak gelakt. Primeur voor @UniUtrecht: eerste 3D-geprinte ‘hoefschoenen’ voor paarden ad.nl/utrecht/primeu…
Nederlands
Utr. Life Sciences retweetledi

Today @HansClevers received the @Keio_Univ Medical Science Prize for his contributions to understanding Wnt signaling in Stem Cells and Organogenesis. Congratulations! @UMCUtrecht @UniUtrecht
Read more: ms-fund.keio.ac.jp/en/prize/024.h…

English
Utr. Life Sciences retweetledi

De nieuwe Vetscience, het magazine van de faculteit Diergeneeskunde, is uit! In dit nummer staat vernieuwing en verandering centraal. De wereld verandert en wetenschap en praktijk veranderen mee, net als de kameleon die de cover siert. Veel leesplezier 👉 uu.nl/organisatie/fa…

Nederlands







